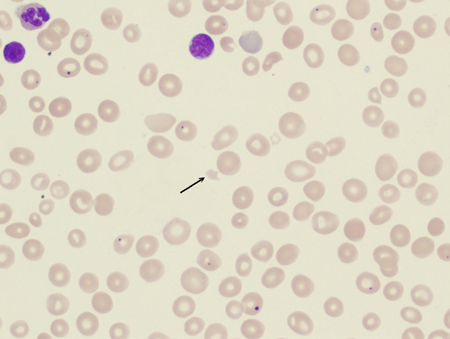
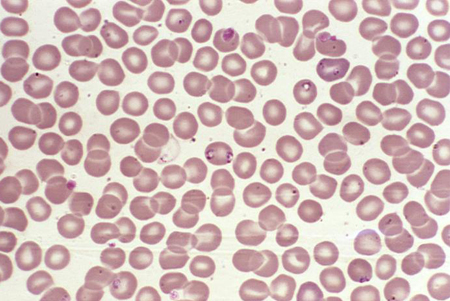

Imágenes y vídeos
Imágenes

Anemia hemolítica
Frotis de sangre periférica con esferocitos, reticulocitos y un eritrocito nucleado
De la colección de John Densmore, Departamento de Medicina, Universidad de Virginia
Ver esta imagen en el contexto de la/s siguiente/s sección/es:
Anemia hemolítica
Frotis de sangre periférica con fragmentos de eritrocitos, o esquistocitos (flecha)
De la colección de John Densmore, Departamento de Medicina, Universidad de Virginia
Ver esta imagen en el contexto de la/s siguiente/s sección/es:

Anemia hemolítica
Micrografía electrónica de barrido coloreada digitalmente que muestra eritrocitos normales y un eritrocito falciforme (izquierda) en una muestra de sangre de un paciente con anemia falciforme
CDC/Sickle Cell Foundation of Georgia: Jackie George, Beverly Sinclair
Ver esta imagen en el contexto de la/s siguiente/s sección/es:
Anemia hemolítica
Fotomicrografía que revela la presencia de lo que se determinó son varios parásitos Babesia sp. intraeritrocitarios en forma de anillo
CDC/Dr. Mae Melvin
Ver esta imagen en el contexto de la/s siguiente/s sección/es:

Anemia hemolítica
Fotomicrografía de un frotis de sangre que muestra eritrocitos que contienen parásitos Plasmodium vivax en desarrollo
CDC/Dr. Mae Melvin
Ver esta imagen en el contexto de la/s siguiente/s sección/es:
Vídeos
Demostración animada de venopunción y flebotomíaCómo tomar una muestra de sangre venosa de la fosa antecubital utilizando una aguja de vacío.
Demostración animada de la canulación venosa periféricaCómo insertar una cánula venosa periférica en el dorso de la mano.
El uso de este contenido está sujeto a nuestra cláusula de exención de responsabilidad